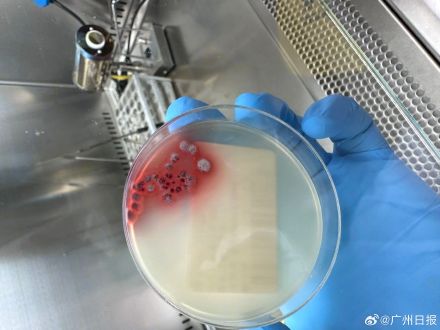
夫妻吃了来偷柑橘的竹鼠后双双肺炎 夫妻吃了来偷柑橘的竹鼠后双双肺炎

近日在浙江温州,一名女子出现咳嗽咳痰伴呼吸费力等症状,就医确诊肺炎,进一步检查提示为“马尔尼菲蓝状菌”感染。
在女子住院期间,其丈夫也出现咳嗽咳痰症状,查胸部CT亦提示肺炎。
医生经询问得知,这对夫妻家有数十亩柑橘园,发病前半个多月发现有竹鼠深夜潜入园中偷食柑橘,遂把这些竹鼠抓住做成菜吃了。
医生指出,竹鼠是马尔尼菲蓝状菌的自然宿主,接触或食用野生竹鼠可能会感染马尔尼菲蓝状菌,免疫力正常人群感染后多能自动清除,免疫力低下患者为易感人群。
马尔尼菲蓝状菌可侵犯人体多个器官与组织,如肺、皮肤、骨髓等,呼吸系统是最常受累部位。拒食野味是预防关键。
点击右上角
微信好友
朋友圈

点击浏览器下方“
”分享微信好友Safari浏览器请点击“
”按钮

点击右上角
QQ

点击浏览器下方“
”分享QQ好友Safari浏览器请点击“
”按钮
